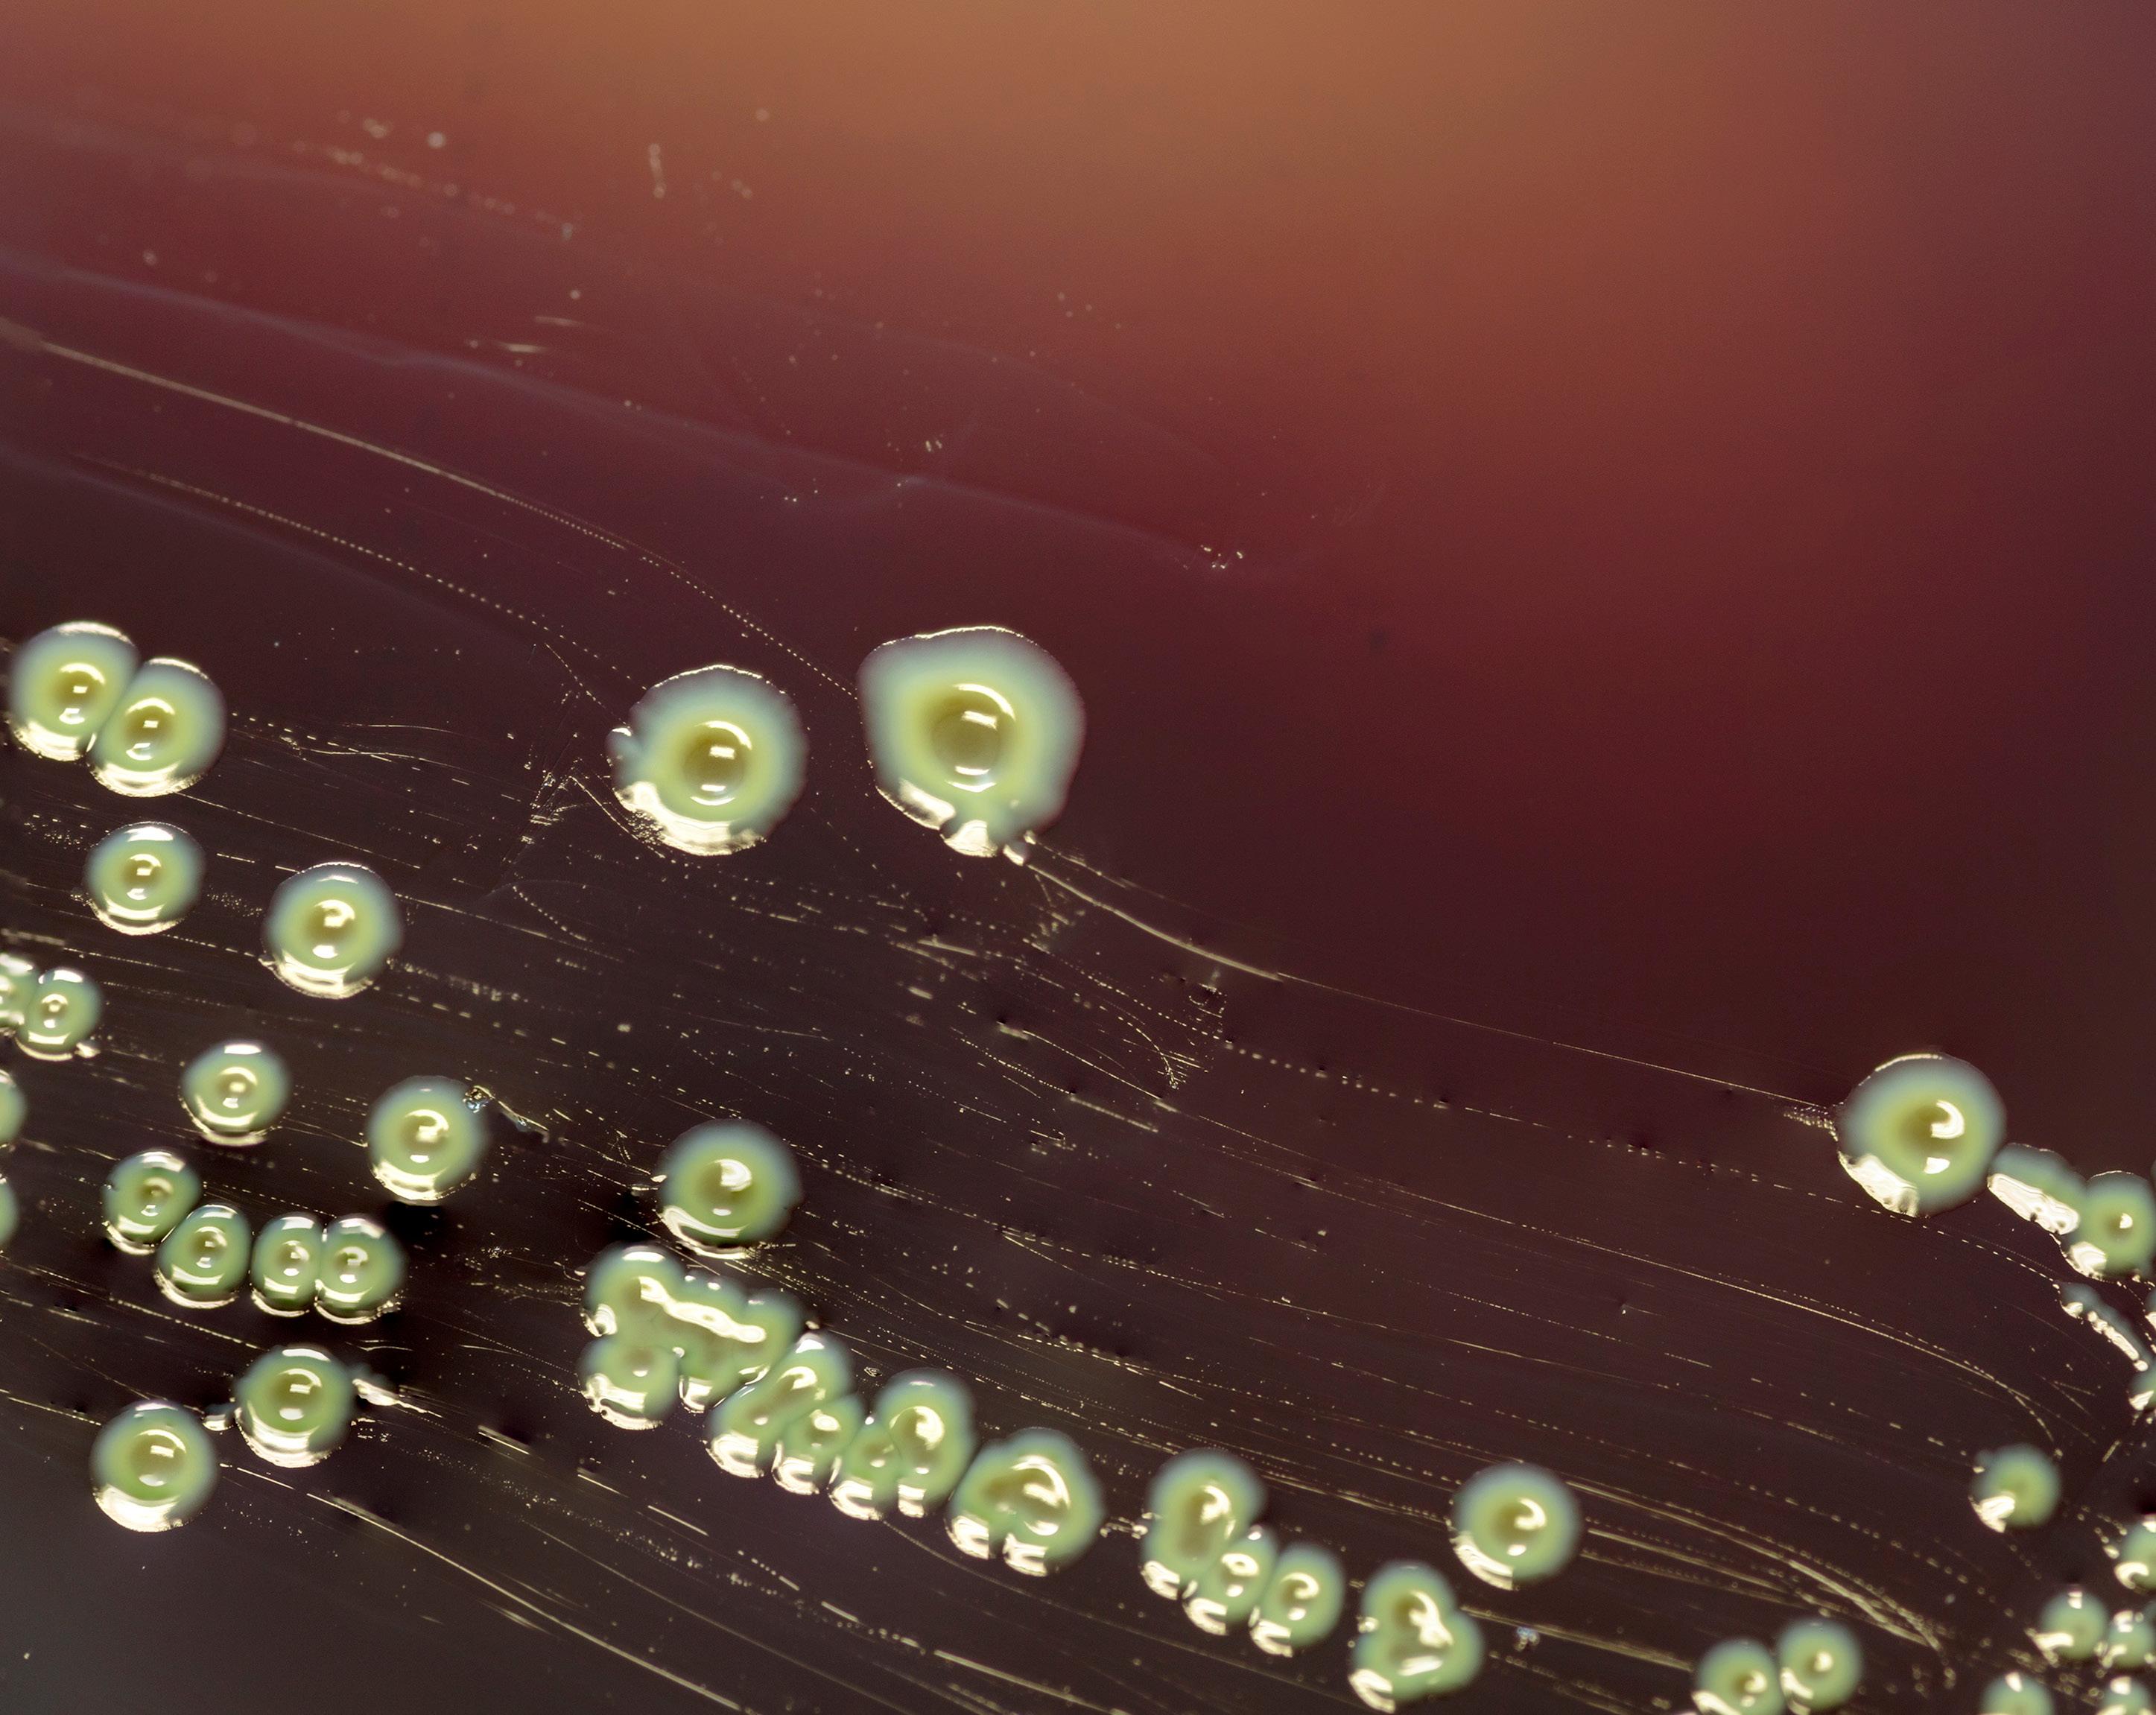
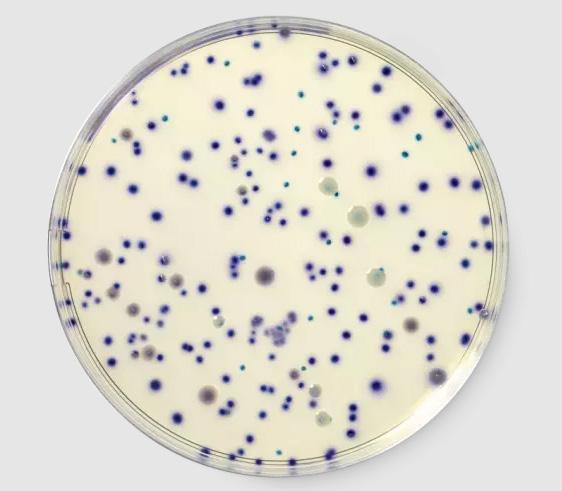

NYHETSBREV 2026 FEBRUARI

Sida 2-3: E.Coli
Sida 4-5: Hygicult
Sida 6-7: CDR Foodlab oil & fat
![]()

Sida 2-3: E.Coli
Sida 4-5: Hygicult
Sida 6-7: CDR Foodlab oil & fat
⹠Escherichia coli (E. coli) Àr en bakterie som vanligtvis finns i tjocktarmen hos varmblodiga organismer. De flesta E.coli-stammar Àr ofarliga, men vissa kan orsaka allvarlig matförgiftning.
⹠Shigatoxinproducerande E. coli (STEC) Àr bakterier som kan orsaka allvarliga livsmedelsburna sjukdomar.
⹠PrimÀra kÀllor till STEC-utbrott Àr rÄa eller dÄligt tillagade köttfÀrsprodukter, obehandlad mjölk och fekal kontaminering av grönsaker.
I de flesta fall Àr sjukdomen sjÀlvbegrÀnsande, men den kan leda till livshotande sjukdom, inklusive hemolytiskt uremiskt syndrom (HUS), sÀrskilt hos smÄ barn och Àldre.
Det finns mÄnga undertyper av E. coli STEC, men nÄgra av de mest kÀnda Àr:
1. E. coli 0157
* Den mest kÀnda och vanligaste orsaken till allvarliga utbrott.
Kan orsaka blodig diarré och i allvarliga fall njursviktt
2. E. coli O26
* Liknar O157, men mindre kÀnd.
* Kan ocksÄ orsaka blodig diarré och allvarliga komplikationer.
3. E. coli 0111
* En annan farlig subtyp.
* Kan leda till allvarliga infektioner och utbrott
4. E. coli 045, 0103, 0121, 0145
* Andra undertyper som ocksÄ kan orsaka sjukdom.
* Inte lika kÀnd som O157, men ÀndÄ farlig.
STEC kan ha olika virulensfaktorer som bidrar till deras förmÄga att orsaka sjukdom. TvÄ viktiga virulensfaktorer Àr stx (Shiga-toxin) och eae (intimin).
STEC kan ha olika virulensfaktorer som bidrar till deras förmÄga att orsaka sjukdom. TvÄ viktiga virulensfaktorer Àr stx (Shiga-toxin) och eae (intimin).

⹠Stx-generna kodar för produktionen av Shiga-toxiner, som Àr potentiellt farliga proteiner.
⹠Dessa toxiner kan skada cellerna i tarmslemhinnan, vilket leder till blodig diarré.
⹠Det finns tvÄ huvudtyper av Shiga-toxiner: Stx1 och Stx2, av vilka Stx2 generellt anses vara mer potent och mer förknippad med allvarliga komplikationer som hemolytiskt uremiskt syndrom (HUS).
⹠eae -genen kodar för ett protein som kallas intimin.
⹠Intimin hjÀlper bakterierna att binda till tarmcellerna, vilket gör det möjligt för dem att kolonisera tarmarna.
⹠Detta leder till bildandet av sÄ kallade "attaching and effacing" lesioner (A/E), dÀr bakterien fastnar pÄ tarmytan och orsakar skador pÄ tarmcellernas struktur.
⹠stx och eae Àr centrala för hur STEC-bakterier orsakar sjukdomar.
⹠NÀrvaron av bÄda generna i en STEC-stam ökar risken för allvarlig sjukdom.
⹠För att skydda dig mot STEC-infektioner Àr det viktigt att ha god hygien och hÄlla koll pÄ livsmedelssÀkerheten
Vi rekommenderar i princip tvÄ olika sÀtt att upptÀcka E.coli. De gÀller bÄde det ofarliga och det farliga.
⹠Chromogena medier: Chromogena medier Àr alternativ till de vanliga metoderna. De Àr vanligtvis enklare och snabbare att anvÀnda. De Àr naturligtvis ocksÄ validerade. RAPID E.coli O157:H7 av AOAC och Afnor, RAPID E.coli2 Àven av Health Canada och Nordval.
⹠Real time-PCR: nÀr det gÀller STEC kommer de flesta att vÀlja att anvÀnda rt-PCR. Det ger, till skillnad frÄn traditionella/kromogena plattor, möjligheten att antingen identifiera vilken specifik serotyp det Àr, eller att identifiera virulensfaktorerna. BÄda delarna kan vara viktiga i förhÄllande till sjukdomsutveckling.
Antalet personer som blivit sjuka av STEC i DK har under de senaste 25 Ären gÄtt frÄn nÀstan inga till över 600/Är. Det finns för nÀrvarande endast grÀnsvÀrde för STEC i groddar, Àven om kött (sÀrskilt köttfÀrs) i vissa fall har misstÀnkts som smittkÀlla. Det första utbrottet vÀrlden över var med serotypen O157:H7 just i köttfÀrs, varför denna nu har fÄtt "smeknamnet" hamburgerbakterien.

Ăr dina yttester NordVal-certifierade?
Om dina tester Ă€r av dĂ„lig kvalitet fĂ„r du alltid dĂ„liga testresultat â du kan inte rĂ€kna med dem. Det finns ingen anledning att löpa onödiga risker för produktĂ„terkallelser eller obehagliga överraskningar för kunderna.
Du kan spara tid och oro genom att anvÀnda rÀtt produkt och vet att du har fullstÀndig kontroll över hygienen. Hygicult kontaktplattor Àr avsedda för tillförlitlig och tidsbesparande övervakning av mikrobiologisk hygien pÄ plats. Hygicult kan Àven anvÀndas som transportmedium om ytterligare analys av proverna krÀvs.
Dip-slides anvÀnds inom livsmedelsindustrin, storkök, delikatessavdelningar, food trucks, sjukhus, tvÀtterier, stÀdindustrin etc. och Àr sÀrskilt anvÀndbara att anvÀnda för sjÀlvkontroll av bÄda ytorna nÀr det inte finns nÄgra
Varför föredrar kunderna
Hygicult framför andra dipslides?
Vissa skÀl Àr mer opraktiska Àn andra, men hÀr Àr nÄgra förslag:
⹠Varje variant av Hygicult har sitt eget fÀrgade lock
⹠Plastdelen Àr svart vilket gör det lÀtt att lÀsa Hygicult
⹠Hygicult Àr robust och tappar inte agar
⹠Ett lÀskort med uppskattade vÀrden ingÄr
⹠Flera av varianterna Àr NordVal-certifierade och/eller
AOAC-validerade


Etablerad metod med lÄng erfarenhet
âą AOAC-validerade metoder.
Certifierad av NKML/NordVal."
⹠LÄng hÄllbarhet.
Förvaring vid rumstemperatur.
âą Inkubation vid omgivande temperatur eller i
Tre enkla steg: prov-Inkubera-tolka.
⹠GÄngjÀrnsplatta för provtagning frÄn ytor Ingen rÀkning av kolonier
Inga mikrobiologiska fÀrdigheter krÀvs
1-2-3
⹠Restaurang och cateringtjÀnster
Tillverkning av drycker
⹠Sjukhus och hÀlsovÄrdsomrÄden
⹠inkubator AnvÀndarvÀnlig
Privata hem och dagvÄrdsomrÄden
TvÀtterier och textiltjÀnster
⹠Inomhus simbassÀnger och spafaciliteter
Gym och fitnesscenter
⹠Skönhetskliniker och tatueringsbutiker
Tillverkning av kosmetika
⹠AnlÀggningar för livsmedelsprodukti-
on: bagerier, mejerier, slakterier, fabriker för bearbetning av fisk
CDR FoodLabŸ fungerar som ett analyslaboratorium. Den har utvecklats för att utföra enkla och snabba kemiska analyser direkt pÄ produktionslinjeneller i laboratoriet, utan personal med erfarenhet av titrering.
CDR FoodLabŸ optimerar traditionella testmetoder, vilket gör dem snabbare och enklare, samtidigt som man sÀkerstÀller att standarderna uppfylls i förhÄllande till ISO-referensmetoderna.

CDR FoodLabŸ fungerar för analys av alla sorters vegetabiliska oljor, men Àven animaliskt fett kan analyseras pÄ instrumentet utan problem.
Det finns inget krav pÄ kalibrering, dÀremot kan filer extraheras frÄn instrumentet sÄ att tillverkaren har möjlighet att kontrollera att det gÄr och fungerar optimalt. Dessutom finns standardlösningar för de flesta analyser, sÄ du har möjlighet att kontrollera att testerna Àr korrekt utförda.
Med CDR FoodLabŸ för oljor och fetter Àr det möjligt att analysera för: fria fettsyror, peroxidtal, anisidintal, jodtal och soaps. Och som nÄgot helt nytt: mÀngden socker i potatisen som anvÀnds till pommes frites och chips.
Och med CDR FoodLabŸ sparar du tid och minimerar förbrukningen av bÄde kemikalier och plastvaror.
Instrumentet Àr kompakt och praktiskt och bestÄr av: en analysenhet med fotometer baserad pÄ LED-teknik och kit med förfyllda kyvetter redo att anvÀndas. Reagenserna speciellt utvecklade av CDR:s laboratorium har lÄg toxicitet och speciella pipetter som gör det möjligt att pipettera rÀtt provvolym.


Varför Àr det sÄ viktigt att kÀnna till sockerhalten i potatis?
Sockerhalten i potatis Àr viktig vid fritering pÄ grund av den kemiska reaktionen som kallas Maillard-reaktionen.

1. Maillard-reaktionen: Denna reaktion sker mellan aminosyror och reducerande sockerarter
vid höga temperaturer och bildar brunfÀrgning och smakutveckling av mÄnga stekta livsmedel. Om potatis har en hög sockerhalt kommer den att brynas snabbare och utveckla en rikare smak och fÀrg.
2. FÀrg: Potatis med högre sockerhalt kan bli vÀldigt mörk eller till och med brÀnnas vid fritering. Detta kan leda till en oönskad mörk fÀrg och potentiellt en brÀnd smak.
3. Smak: Sockerhalten pĂ„verkar smaken. Ăven om en viss grad av bryning Ă€r önskvĂ€rt för att ge pommes frites eller annan friterad potatis en god smak, kan för mycket socker resultera i en bitter eller brĂ€nd smak.
4. Konsistens: Sockerhalten kan ocksÄ pÄverka konsistensen pÄ potatisen. Potatis med lÄg sockerhalt tenderar att vara krispigare, vilket Àr önskvÀrt för mÄnga friterade potatisrÀtter som pommes frites.
5. Akrylamid: Reducerande sockerarter som glukos och fruktos reagerar med asparaginsyra under upphettning (en del av Maillard-reaktionen) för att bilda akrylamid. Potatis med högre sockerhalt Àr dÀrför mer benÀgna att bilda mer akrylamid nÀr den friteras. Akrylamid misstÀnks vara cancerframkallande, och dÀrför finns det ett intresse för att minimera dess bildning i livsmedel.

Av dessa skÀl görs ofta försök att kontrollera och anpassa sockerhalten i potatis avsedd för fritering.Potatis kan till exempel förvaras vid lÄga temperaturer (men inte för lÄga, eftersom detta kan öka sockerhalten) och bearbetas pÄ sÀtt som hjÀlper till att balansera sockerhalten för att uppnÄ önskad fÀrg, smak och konsistens.
Med CDR FoodLabŸ för oljor och fetter Àr det enkelt och snabbt att fÄ ett exakt vÀrde för bÄde glukos och fruktos separat och totalt i mÀtomrÄdet 5-2500 mg/kg.

NÀr vi tÀnker pÄ blod tÀnker vi ofta pÄ fÀrgen röd, dÄ vi oftast associeras detta med blod frÄn ryggradsdjur med jÀrninnehÄllande hemoglobin. Men djurriket döljer en fascinerande palett av alternativa fÀrger nÀr det gÀller livgivande blod.
Biokemi

Àmne som gör vÄra blÄmÀrken gröna). Normalt Àr Àmnet giftigt, men dessa ödlor har sÄ stora mÀngder av det att det överskuggar det röda hemoglobinet.
Runi Nielsen
MÄnga blötdjur och leddjur, som t.ex blÀckfiskar, hÀstskokrabbor och humrar har blÄtt blod.
FĂŠrĂžerne
Danmark
Cristiana@foodiagnostics.dk
Telefon: 2594 8086
· Varför? Deras blod anvÀnder proteinet hemocyanin för att transportera syre. DÀr vÄrt blod anvÀnder jÀrn (som rostar och blir rött), anvÀnder de koppar. NÀr koppar binder till syre Àndrar den fÀrg till en djup blÄ.
Tonny NielEhsan Mirsharghi Mikrobiologi
Hygiejne & ECA
NÄgra marina ryggradslösa djur och vissa armfotingar (Brachiopoda) har lila blod.
Runi@foodiagnostics.dk
Danmark
Telefon: (298) 591667
· Fördelen: Hemocynin fungerar bÀttre Àn hemoglobin i kalla, syrefattiga miljöer, vilket gör det perfekt för djuphavsbor.
Grönt blod finns i vissa typer av marina borstmaskar och en mycket speciell grupp ödlor frÄn Nya Guinea.
· Marina maskar: De anvÀnder proteinet klorokruorin. Det liknar mycket vÄrt hemoglobin, men i en nÄgot modifierad form som gör blodet ljusgrönt nÀr det Àr syreförsatt (och mörkgrönt i syrefattigt tillstÄnd).
· Prasinohaema-ödlor: Dessa ödlor har grönt blod av en helt annan anledning. Deras blod Àr fyllt med en avfallsprodukt som kallas biliverdin (samma

Danmark
Tonny@foodiagnostics.dk
Telefon: 4056 5659
Ehsan@foodiagnostics.dk Telefon: 2222 7592
· Varför? De anvÀnder proteinet hemerytrin. NÀr blodet saknar syre Àr det genomskinligt, men sÄ snart det binder sig till syre Àndras det till en intensiv violett eller lila fÀrg. Den Àr dock inte sÀrskilt effektiv för syretransport jÀmfört med de andra typerna.
MÄnga insekter har varken rött, blÄtt, lila eller grönt blod. Deras vÀtska kallas hemolymf.
· Varför? Eftersom insekter andas genom smÄ rör i kroppen (luftstrupe) behöver deras blod inte transportera syre. DÀrför saknar de ofta fÀrgpigment helt och hÄllet. Den kan dock se gulaktig eller blekgrön ut pÄ grund av maten de Àter.
Blodets fÀrg Àr aldrig slumpmÀssig. Det handlar om kemi och överlevnad. Oavsett om det Àr koppar i det iskalla havet eller jÀrn pÄ savannen, har naturen hittat precis rÀtt "recept" för liv baserat pÄ de förutsÀttningar som finns i miljön.
Ladda ner bestÀllningsblankett för kalibreringskontroll.
Fyll i och skicka med mÀtaren. Följ instruktioner för frakt.
LÀs mycket mer pÄ vÄr hemsida.




Scandinavian Diagnostics AB Norra à gaten 10 41664 Göteborg
Sverige
Tlf: 031-792 2020
Mail: order@scandiagnostics.se
www.scandiagnostics.se och anmÀl dig till vÄrt digitala nyhetsbrev eller 'följ' oss pÄ Facebook och LinkedIn



